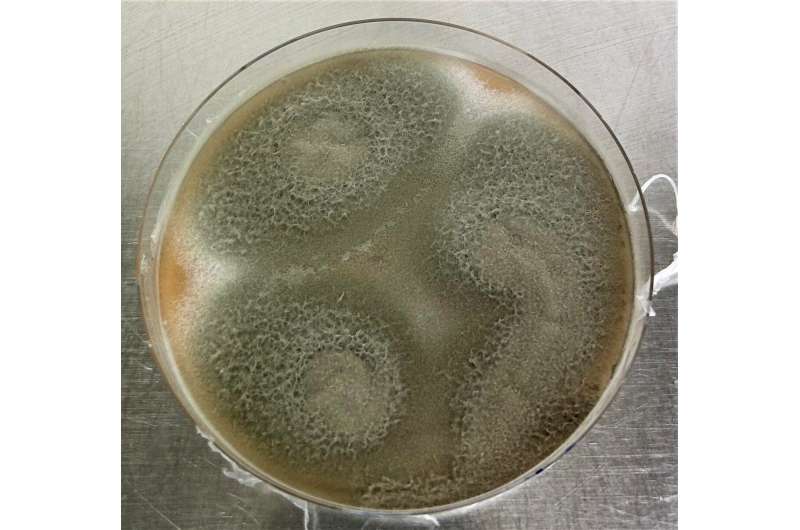
Fungus Converts Cellulose into Erythro-isocitric Acid: A Sustainable Chemical Production Method

The fungus Talaromyces verruculosus can produce the chemical erythro-isocitric acid directly from cheap plant waste, thus making it interesting for industrial utilization.
Using the natural abilities of the non-genetically modified fungus, a research team from Jena has discovered a method for the efficient conversion of cellulose into a form of isocitric acid. The new production method could significantly simplify the previously complex and multi-stage process for obtaining platform chemicals from cellulose by requiring only a single bioprocess.
Thanks to the new cost-effective method, the rarely utilized sister molecule of the intensively used citric acid can benefit a sustainable circular economy—provided there is a market for it.
The study was published by a research team from the Leibniz Institute for Natural Product Research and Infection Biology—Hans Knöll Institute (Leibniz-HKI) in the journal ACS Sustainable Chemistry & Engineering.
As natural metabolic products of most living organisms, citric acid and isocitric acid are among the most widespread acids in nature. Citric acid is produced industrially in large quantities using the mold fungus Aspergillus niger. With an annual production of around 2.8 million tons worldwide, it is one of the highest-volume biotechnological products of all.
Its range of applications is enormous: whether as a descaling agent, preservative, care product or flavor enhancer—the versatile natural chemical is an important and also cheap additive in industry, as biotechnological production is extremely efficient and uncomplicated.
The production of bioplastics and biofuels from citric acid is also technically possible. However, as citric acid is produced from sugar and is therefore in direct competition with food production, these fields of application have so far been neither economical nor sustainable. In fact, the production of citric acid currently consumes more than 1% of global sugar production.
Isocitric acid is very similar to citric acid, only one hydroxyl group is positioned on a different carbon atom. This makes the molecule asymmetric and there are two different variants, known as diastereomers, which are referred to as threo- and erythro-isocitric acid. Each diastereomer has two mirror-image variants, the D- and L-forms.
Citric acid and isocitric acid have almost identical properties and it can be assumed that the iso form would be just as widely applicable. The reason why this is not the case is that there has not yet been an efficient production process for pure isocitric acid, so it is currently only available as a research chemical.
One kilogram of the substance at the moment costs about 18,000 euros. However, the new production process enables sustainable and inexpensive production from plant waste and residues such as straw, waste paper or wood residues, which could make it possible to produce isocitric acid even more cheaply than citric acid in the future.
Until now, a complex, three-stage process was required to use such renewable source materials. Expensive enzymes were needed to first break down the cellulose enzymatically into sugar so that it could finally be utilized by the microorganisms.
One fungus—one process
A promising approach is so-called consolidated bioprocessing (CBP), in which various process steps are combined into a single one using suitable microorganisms. The star of the new biotechnological procedure is the mold Talaromyces verruculosus.
In screening tests, first author Ivan Schlembach discovered that the wild type of T. verruculosus isolated from nature can convert lignocellulose directly into erythro-isocitric acid, en masse and very efficiently in a single process in which the fungus itself produces all the enzymes required for this.
In experiments, the researchers determined the ideal conditions for cellulose degradation and the production of isocitric acid, including factors such as nitrogen content, pH value, temperature and nutrient concentration. They also developed new methods to accurately measure the activity of the enzyme cellulase, which is crucial for the degradation of cellulose, during the fermentation process. This enables optimal control of the production process.
Miriam Rosenbaum heads the Bio Pilot Plant at the Leibniz-HKI and is Professor of Synthetic Biotechnology at the Friedrich Schiller University Jena. She explains, "T. verruculosus has the unique ability to convert lignocellulose directly into erythro-isocitric acid with remarkable efficiency.
"It does this at a rate comparable to the conversion of glucose, which is used in the laboratory as a starting material for the fermentation process. With the fungus, we have developed a simpler and cheaper process."
Isocitric acid can be easily converted chemically into itaconic acid, for which there is already a great demand for the production of sustainable plastics and coatings. If erythro-isocitric acid is readily available, there should therefore be no shortage of customers.
However, there is the same hurdle as for any new substance: as erythro-isocitric acid has not been available in large quantities to date, the market for it must first be established.
The significantly cheaper process that has now been developed opens up new possibilities and applications.
Another special feature is the fact that only erythro-isocitric acid is formed in the process and not a mixture of different diastereomers. This makes the molecule particularly interesting for special applications, for example in the pharmaceutical industry.
In the case of drugs, often only one diastereomer is effective, so it has to be laboriously isolated from the mixture of both variants. Erythro-isocitric acid can serve as a valuable chiral building block for chemical syntheses.
The specific biological properties of erythro-isocitric acid have been little studied to date. However, many useful properties have been demonstrated for the sister molecule threo-isocitric acid.
The latter can be a valuable addition to citric acid, particularly in the medical, pharmaceutical, cosmetics or food industries, for example, as a chelating agent, as an anticoagulant in blood samples, as a functional food supplement, as an ingredient in cosmetics, as a preservative or as an anti-aging compound in lifestyle products.
The findings underline that organisms such as T. verruculosus can enable the sustainable utilization of biowaste and make the production of valuable chemicals from renewable biomass economically viable.
"Nature holds enormous potential to tackle global sustainability challenges. The fungus T. verruculosus lays the foundation for a low-cost green technology, and there are also many industrial uses for isocitric acid. The only thing missing at the moment is the market's openness to the new process," emphasizes Ivan Schlembach.
The research team is now working on further optimizing the process and elucidating the biochemical reactions involved in the formation of isocitric acid. By refining biochemical parameters, the researchers from Jena hope to contribute to the transition to a sustainable and resource-efficient bioeconomy.
In the future, they want to work with interested industrial partners to find out whether the procedure, which has now been patented, can also hold its own on the market.
More information: Ivan Schlembach et al, Nonengineered Fungus Provides a Shortcut from Cellulose to Bulk Erythro-isocitric Acid, ACS Sustainable Chemistry & Engineering (2024). DOI: 10.1021/acssuschemeng.3c04664
Journal information: ACS Sustainable Chemistry & Engineering
Provided by Leibniz-Institut für Naturstoff-Forschung und Infektionsbiologie - Hans-Knöll-Institut (Leibniz-HKI)